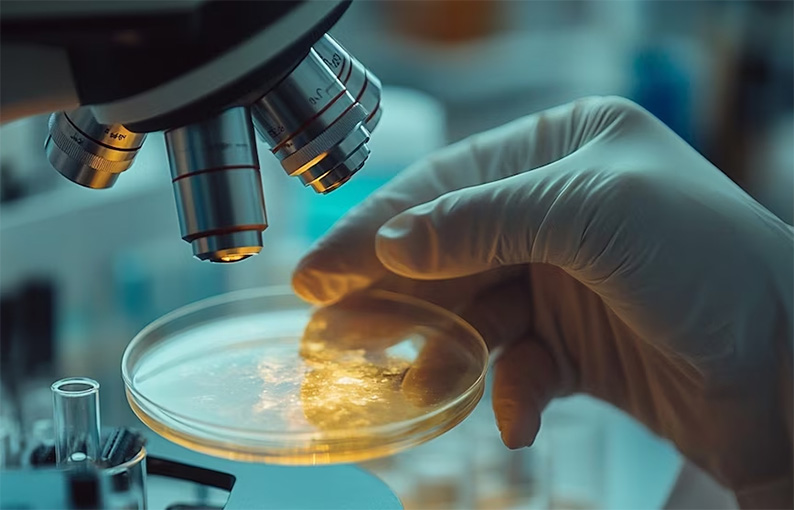

Experimentos inéditos en laboratorios, ensayos médicos a gran escala y ambiciosas misiones interplanetarias marcarán la agenda del próximo año. El repaso de la icónica revista,
La ciencia global se prepara para un año intenso, donde distintos proyectos prometen marcar el rumbo de la investigación y la tecnología. Desde desarrollos en inteligencia artificial hasta misiones espaciales y grandes estudios clínicos, los avances se enfrentan tanto a ambiciones crecientes como a nuevos desafíos. Estos hitos configuran la hoja de ruta de la investigación para 2026 y podrían tener impactos en la vida cotidiana, el conocimiento humano y la medicina.
De acuerdo con la revista científica Nature, los protagonistas emergen de laboratorios de todo el mundo. En este escenario cobran relieve nuevos experimentos con edición genética, avances en la exploración espacial y proyectos de física de partículas. La expectativa recae también sobre el uso de la inteligencia artificial en las ciencias básicas y aplicadas.
Actualizaciones clínicas y ensayos con IA
El uso de la inteligencia artificial (IA) para potenciar la labor científica ganó terreno durante el último año. Según Nature, los llamados “agentes” impulsados por IA, que integran distintos modelos de lenguaje avanzados, ya realizan tareas complejas con poca intervención humana y se encuentran cerca de concretar descubrimientos de alto impacto. Uno de los desafíos que enfrentan consiste en los errores que pueden aparecer en los sistemas, como la eliminación inadvertida de datos críticos.
Además, las innovaciones tecnológicas exploran modelos de menor escala capaces de aprender a partir de pequeños conjuntos de información y de especializarse en resolución de problemas lógicos. Esta estrategia optimiza recursos, ya que los modelos grandes de IA implican costos elevados en su entrenamiento. Uno de estos sistemas compactos superó a los grandes modelos en pruebas de lógica, lo cual genera expectativa por su potencial de aplicación.
Misiones para explorar la Luna y Marte

El año próximo tendrá un calendario activo en exploración espacial, donde destacan las próximas misiones a la Luna y a la órbita de Marte. La Administración Nacional de Aeronáutica y el Espacio (NASA) prepara el lanzamiento de Artemis II, la primera misión tripulada alrededor del satélite terrestre desde la década de 1970. El vuelo de diez días ayudará a planificar futuros aterrizajes en la superficie lunar.
Por su parte, China proyecta el envío del artefacto Chang’e-7 hacia el polo sur lunar, un desafío técnico por sus condiciones rocosas y la abundancia de cráteres. Nature puntualizó que, si aterriza correctamente, la misión buscará rastros de hielo y analizará los sismos lunares.
A estas iniciativas se suma el plan de Japón de lanzar la misión MMX para explorar y recolectar muestras de Fobos y Deimos, las dos lunas de Marte. El material se traerá a la Tierra en 2031, en un esfuerzo inédito, según lo indicado por la publicación científica.
En tanto, la Agencia Espacial Europea (ESA) alista el lanzamiento de PLATO, un satélite equipado con 26 cámaras dirigido a observar más de 200.000 estrellas y buscar planetas con condiciones similares a la Tierra. Nature agregó que este instrumento situará especial interés en identificar mundos donde pueda existir agua líquida.
Observación solar continua

Por otro lado, la observación del Sol experimenta un avance destacado gracias a la misión Aditya-L1 de la India. Este satélite se encuentra en una órbita especial, conocida como órbita de halo, a 1,5 millones de kilómetros de la Tierra. Su posición le permite observar el Sol de forma continua, sin interrupciones causadas por la sombra de la Tierra o la Luna.
El satélite estudia el periodo de mayor actividad del astro, una etapa en la que aparecen numerosas manchas solares y se producen tormentas intensas en la superficie. Los datos obtenidos ayudarán a los científicos a comprender mejor cómo se comporta el Sol durante esta fase de su ciclo.
Ensayos médicos y cambios regulatorios
La medicina también tiene en agenda experimentos a gran escala. El Reino Unido avanza hacia la publicación de los resultados de un enorme ensayo sobre una prueba de sangre capaz de detectar cerca de 50 tipos de cáncer antes del inicio de síntomas.
Esta tecnología se centra en segmentos de ADN liberados por células cancerígenas, y el ensayo incluyó la participación de más de 140.000 voluntarios. Nature reportó que, de obtener resultados alentadores, el Servicio Nacional de Salud planea incorporar la herramienta en numerosos hospitales del territorio.

Desde abril, el Reino Unido también se prepara para concretar la mayor actualización normativa en ensayos clínicos en dos décadas. Nature explicó que con la nueva ley, investigadores podrán gestionar una única solicitud para permisos éticos y regulatorios, y requiere publicar resúmenes de resultados en un año. Esto apunta a acelerar la investigación y ampliar la diversidad de los participantes.
Los avances en regulaciones llegan también a Estados Unidos, donde la Administración de Alimentos y Medicamentos (FDA) empezó a considerar la aprobación de medicamentos con un solo ensayo clínico. Este cambio seguirá definiéndose durante 2026, según lo informado por la revista.
Impulso a la edición genética
El caso de KJ Muldoon marcó un precedente en la aplicación de edición genética personalizada. El niño nació con una enfermedad genética que impedía a su cuerpo metabolizar proteínas debido a una mutación que afectaba la producción de una enzima esencial. Según Nature, fue el primer paciente en recibir una terapia CRISPR diseñada exclusivamente para corregir su mutación específica.
A los pocos meses de vida, y ante el riesgo de daño cerebral grave o muerte, recibió tres dosis del tratamiento. El procedimiento, desarrollado en solo seis meses por un equipo internacional del Children’s Hospital of Philadelphia, incluyó tecnología de edición de bases, una técnica capaz de modificar una sola letra del ADN.
Tras la primera dosis, Muldoon pudo aumentar su ingesta de proteínas, y con las dosis posteriores se redujo la necesidad de medicamentos para controlar sus niveles de amoníaco en sangre. Aunque los médicos aclaran que es pronto para hablar de cura, los resultados iniciales sorprendieron a los especialistas. Su terapia, adaptada exclusivamente a su perfil genético, representa un enfoque poco habitual y difícil de aplicar de forma general, dado el alto costo y la complejidad.
Según Nature, el equipo médico responsable prepara un ensayo clínico en Filadelfia para aplicar este tipo de tratamiento a más niños que tienen trastornos metabólicos poco frecuentes, todos provocados por cambios en siete genes identificados. Además, otro grupo de investigadores tiene previsto iniciar ensayos con este método para tratar enfermedades genéticas que afectan al sistema inmunológico en niños.
Proyectos de física y océanos profundos
En territorio científico, la física de partículas y la geología subacuática también agendan nuevas iniciativas. El Gran Colisionador de Hadrones (LHC), principal acelerador de partículas del mundo ubicado en Suiza, se dispone a realizar su última serie de experimentos antes de someterse a una importante actualización técnica para cuadruplicar su potencia, conocida como “alta luminosidad”. Nature informó que esta intervención permitirá experimentos con mayor precisión a partir de 2030.

Entre tanto, el Fermi National Accelerator Laboratory (Fermilab) de Illinois prevé finalizar la construcción del detector Mu2e. Su objetivo será averiguar si el muón, partícula subatómica efímera, puede convertirse en electrón sin emitir otras partículas. Al concluir el montaje, el laboratorio dedicará un periodo al ajuste de magnetos, y la recolección de datos se proyecta para 2027.
La exploración del planeta recibe un impulso con la misión del barco chino Meng Xiang, diseñado para perforar hasta 11 kilómetros en la corteza oceánica y obtener muestras del manto terrestre. Este logro permitiría comprender mejor la formación del fondo marino y los motores de la tectónica de placas.
Por Camila Caruso (Infobae)






